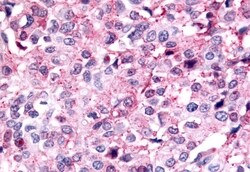
Invitrogen PAK6 Polyclonal Antibody 50 &mu;g; Unconjugated:Antibodies,

missing translation for 'onlineSavingsMsg'
Learn More
Learn More
Invitrogen™ PAK6 Polyclonal Antibody


Rabbit Polyclonal Antibody
Brand: Invitrogen™ PA534100
This item is not returnable.
View return policy
Description
Percent identity with other species by BLAST analysis: Human, Gorilla, Orangutan, Gibbon, Monkey, Marmoset, Dog, Horse (100%) Goat, Elephant, Panda, Rabbit (94%).
PAK6 is a serine/threonine kinase expressed in the testis and prostate. It associates with both the estrogen and androgen receptors. The p21-activated kinases (PAKs) are serine-threonine kinases that bind to the active forms of Cdc42 and Rac. They are divided into two groups, the first of which include PAK1, 2 and 3, and can be activated by Cdc42/Rac binding. Group 1 PAKs contain an autoinhibitory domain whose activity is regulated by Cdc42/Rac binding. The group 1 PAKs are known to be involved in cellular processes such as gene transcription, apoptosis, and cell morphology and motility. Much less is known about the second group, which includes PAK4, 5 and 6. These proteins are not activated by Cdc42/Rac binding. Later experiments have shown it to be activated by MAP kinase kinase 6 and p38 MAP kinase, suggesting that PAK6 may play a role in the cellular response to stress-related signals.
Specifications
| PAK6 | |
| Polyclonal | |
| Unconjugated | |
| Pak6 | |
| 4732456M09; p21 (CDKN1A)-activated kinase 6; p21 (RAC1) activated kinase 6; p21 protein (Cdc42/Rac)-activated kinase 6; p21(CDKN1A)-activated kinase 6; p21-activated kinase 6; PAK5; PAK-5; PAK6; PAK-6; Serine/threonine-protein kinase PAK 6 | |
| Rabbit | |
| Antigen affinity chromatography | |
| RUO | |
| 100071463, 100856038, 56924 | |
| Store at 4°C short term. For long term storage, store at -20°C, avoiding freeze/thaw cycles. | |
| Liquid |
| Immunohistochemistry (Paraffin) | |
| 1 mg/mL | |
| PBS with 0.1% sodium azide | |
| Q9NQU5 | |
| Pak6 | |
| Synthetic 18 amino acid peptide from Linker domain of human PAK6. | |
| 50 μg | |
| Primary | |
| Human, Canine, Monkey, Horse | |
| Antibody | |
| IgG |
Product Content Correction
Your input is important to us. Please complete this form to provide feedback related to the content on this product.
Product Title
Spot an opportunity for improvement?Share a Content Correction